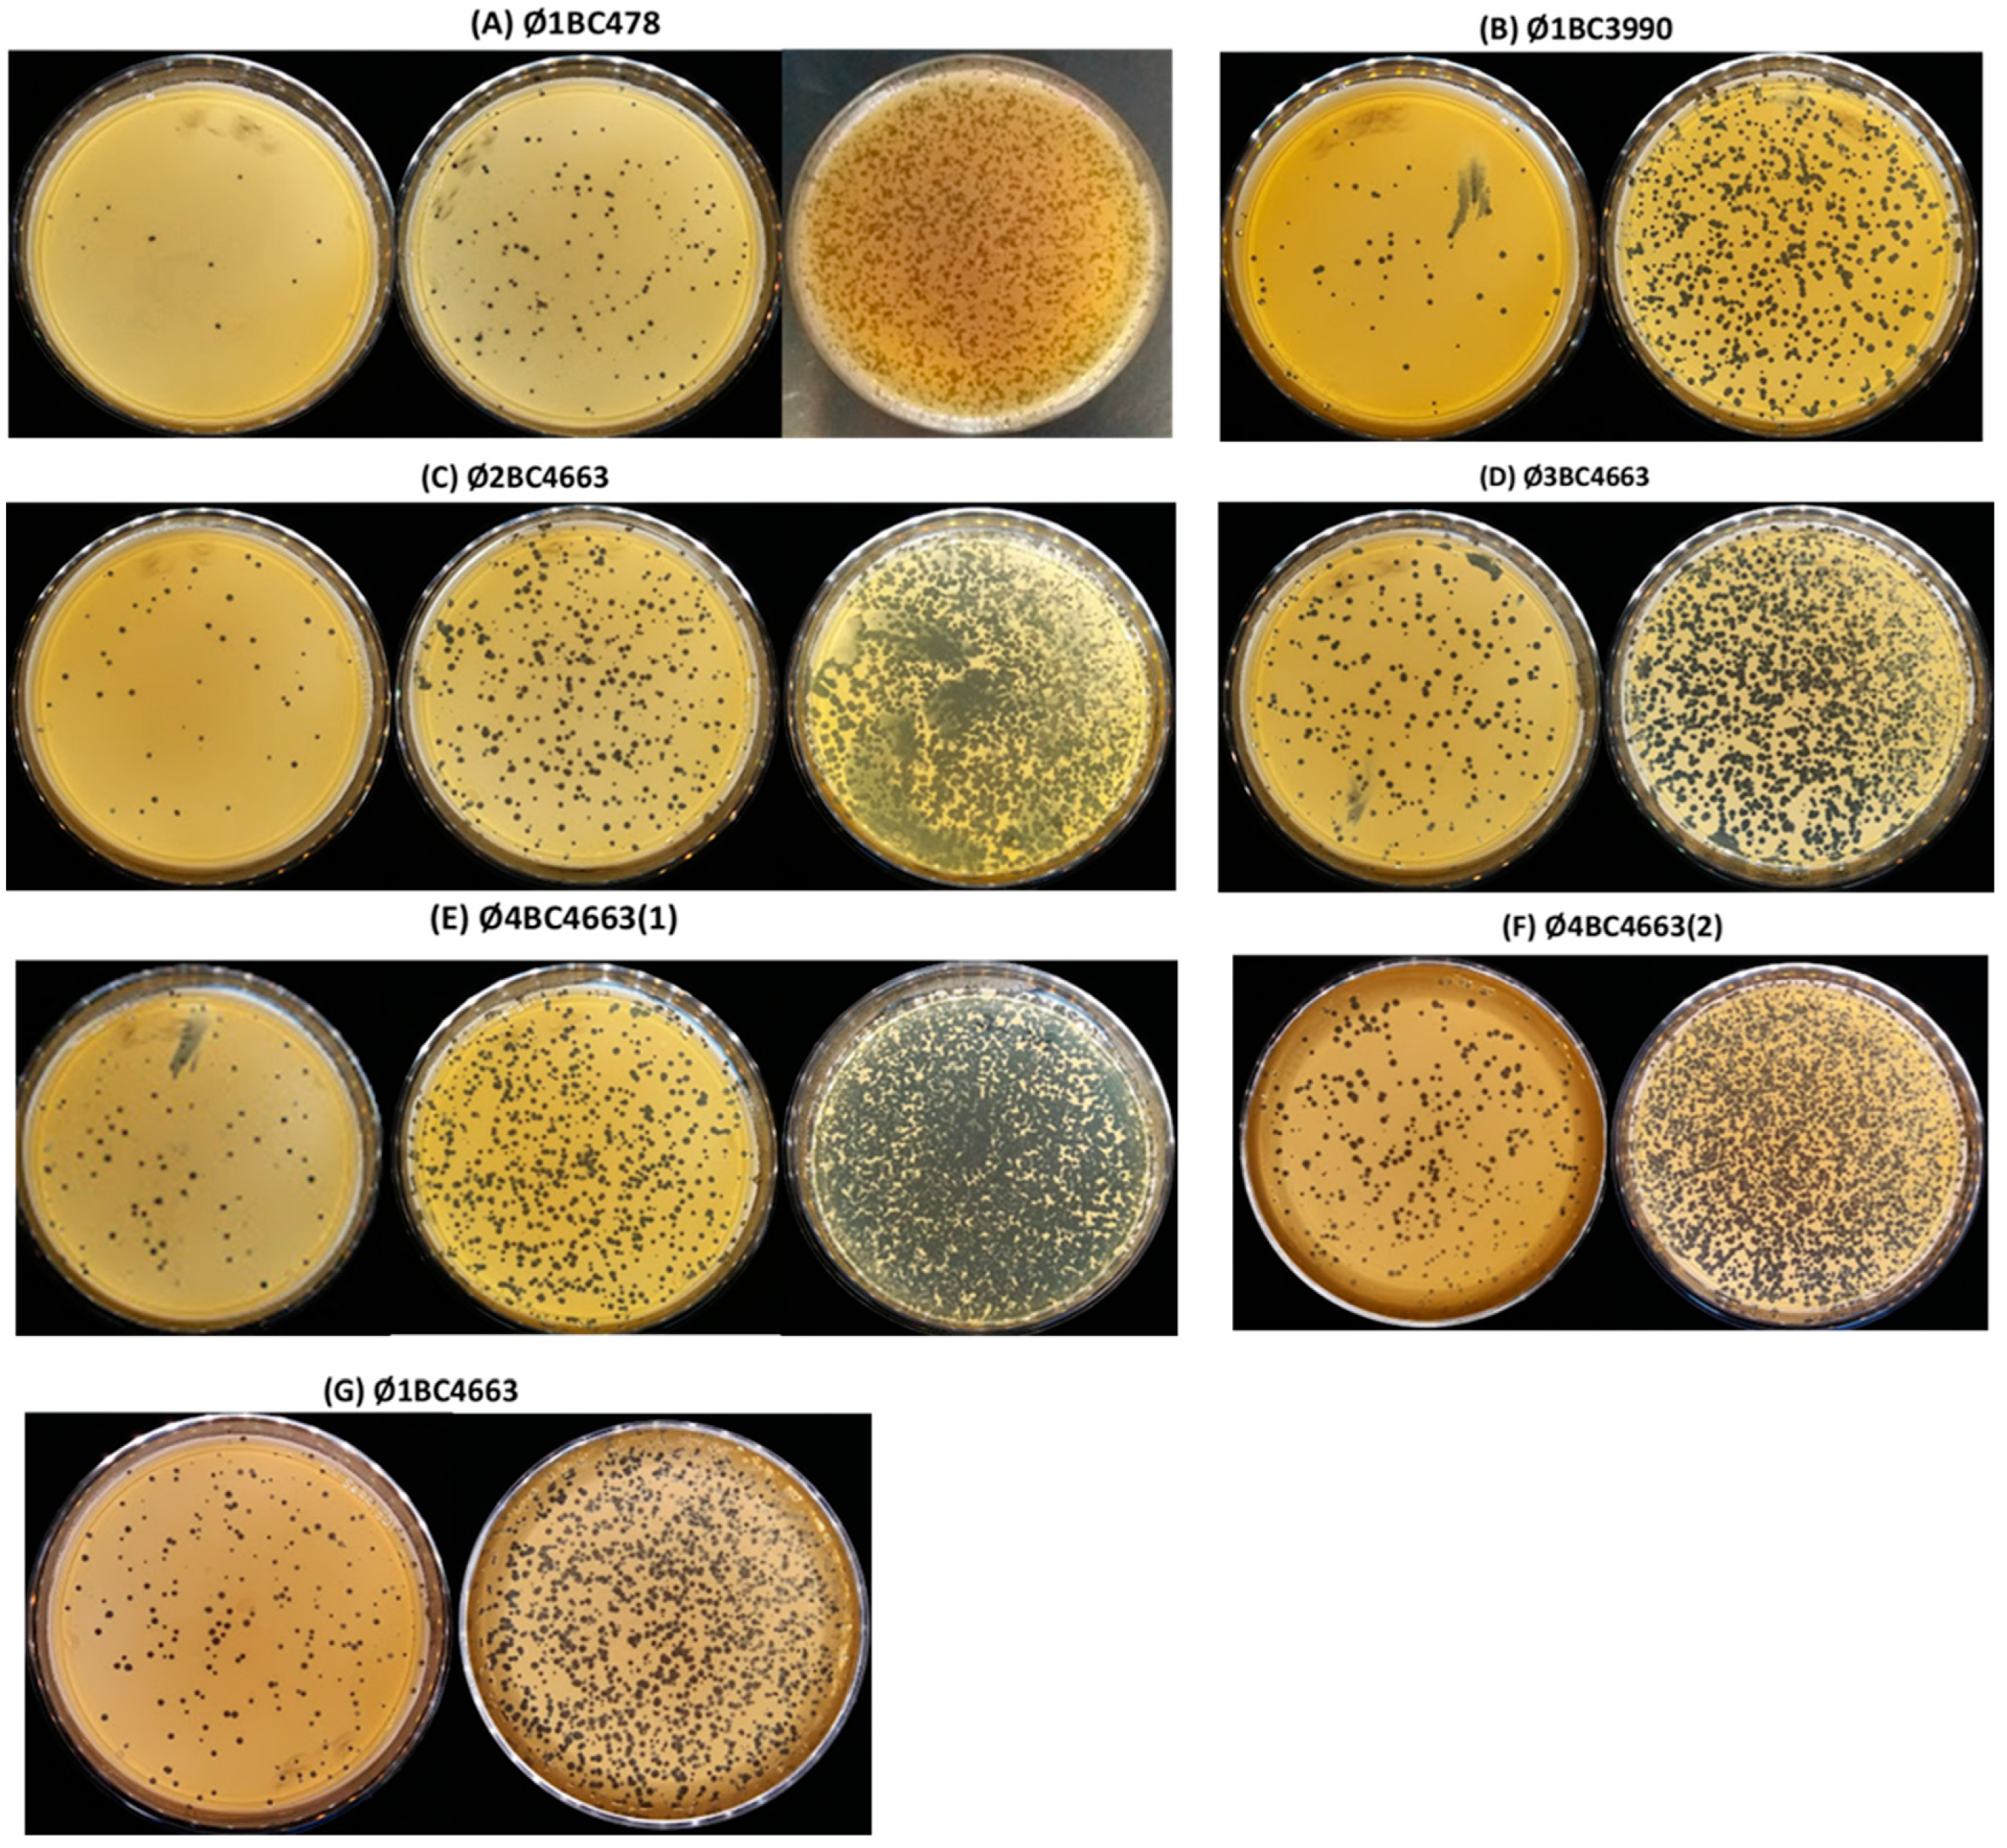
Pathogens 11 00872 g001

Isolation, Partial Characterization and Application of Bacteriophages in Eradicating Biofilm Formation by Bacillus cereus on Stainless Steel Surfaces in Food Processing Facilities
Abstract
:1. Introduction
2. Results
2.1. Isolation and Host Spectrum Evaluation of Bacteriophages
2.2. Bacteriophage Characterization
2.2.1. Morphological Observation
2.2.2. Protein Pattern Analysis
2.2.3. Restriction Enzyme Digestion Pattern Analysis
2.3. Bacteriophage Action on B. cereus Biofilms
2.3.1. Effectiveness of Phage Treatment in Reducing Pre-formed Biofilms
2.3.2. Effectiveness of Phage Treatment in Inhibiting Biofilms
3. Discussion
4. Materials and Methods
4.1. Bacterial Strains and Culture Conditions
4.2. Isolation of B. cereus-Specific Phages and Host Spectrum Evaluation
4.2.1. Sampling
4.2.2. Enrichment Phase
4.2.3. Phage Isolation, Propagating and Purifying
4.2.4. Host Range Assay
4.3. Bacteriophage Characterization
4.3.1. High-Titer Phage Stock Preparation
4.3.2. Morphology Observation by Transmission Electron Microscopy
4.3.3. Structural Protein Analysis
4.3.4. Restriction Digest Profile Analysis of B. cereus Bacteriophages
4.4. Assessment of Bacteriophage Action on B. cereus Biofilms
4.4.1. Preparation of Stainless Steel Coupons
4.4.2. Reducing Pre-Formed Biofilm Experiment (Phage Post-Treatment)
4.4.3. Inhibiting Biofilm Formation Experiment (Phage Treatment)
5. Conclusions
Supplementary Materials
Author Contributions
Funding
Institutional Review Board Statement
Informed Consent Statement
Data Availability Statement
Conflicts of Interest
References
- Granum, P.E. Bacillus cereus and its toxins. J. Appl. Bacteriol. 1994, 76, 61–66. [Google Scholar] [CrossRef]
- Branda, S.S.; Vik, S.; Friedman, L.; Kolter, R. Biofilms: The matrix revisited. Trends Microbiol. 2005, 13, 20–26. [Google Scholar] [CrossRef] [PubMed]
- Flemming, H.C.; Wingender, J. The biofilm matrix. Nat. Rev. Microbiol. 2010, 8, 623–633. [Google Scholar] [CrossRef] [PubMed]
- Peng, J.S.; Tsai, W.C.; Chou, C.C. Inactivation and removal of Bacillus cereus by sanitizer and detergent. Int. J. Food Microbiol. 2002, 77, 11–18. [Google Scholar] [CrossRef]
- Marchand, S.; De Block, J.; De Jonghe, V.; Coorevits, A.; Heyndrickx, M.; Herman, L. Biofilm formation in milk production and processing environments; influence on milk quality and safety. Compr. Rev. Food Sci. Food Saf. 2012, 11, 133–147. [Google Scholar] [CrossRef]
- Rajkovic, A.; Uyttendaele, M.; Dierick, K.; Samapundo, S.; Botteldoorn, N.; Mahillon, J.; Heyndrickx, M. Risk Profile of the Bacillus cereus Group Implicated in Food Poisoning. Rep. Super. Health Counc. Belg. 2008, 1, 1–80. [Google Scholar]
- Tauveron, G.; Slomianny, C.; Henry, C.; Faille, C. Variability among Bacillus cereus strains in spore surface properties and influence on their ability to contaminate food surface equipment. Int. J. Food Microbiol. 2006, 110, 254–262. [Google Scholar] [CrossRef]
- Van Houdt, R.; Michiels, C.W. Biofilm formation and the food industry, a focus on the bacterial outer surface. J. Appl. Microbiol. 2010, 109, 1117–1131. [Google Scholar] [CrossRef] [Green Version]
- Srey, S.; Jahid, I.K.; Do Ha., S. Biofilm formation in food industries: A food safety concern. Food Control 2013, 31, 572–585. [Google Scholar] [CrossRef]
- Corbin, B.D.; Mclean, R.J.C.; Aron, G.M. Bacteriophage T4 multiplication in a glucose-limited Escherichia coli biofilm. Can. J. Microbiol. 2001, 47, 680–684. [Google Scholar] [CrossRef]
- Teng, F.; Singh, K.V.; Bourgogne, A.; Zeng, J.; Murray, B.E. Further Characterization of the epa Gene Cluster and Epa Polysaccharides of Enterococcus faecalis. Infect. Immun. 2009, 77, 3759–3767. [Google Scholar] [CrossRef] [PubMed] [Green Version]
- Hibma, A.M.; Jassim, S.A.A.; Griffiths, M.W. Infection and removal of L-forms of Listeria monocytogenes with bred bacteriophage. Int. J. Food Microbiol. 1997, 34, 197–207. [Google Scholar] [CrossRef]
- Soni, K.A.; Nannapaneni, R. Removal of Listeria monocytogenes Biofilms with Bacteriophage P100. J. Food Prot. 2010, 73, 1519–1524. [Google Scholar] [CrossRef] [PubMed]
- Sillankorva, S.; Neubauer, P.; Azeredo, J. Pseudomonas fluorescens biofilms subjected to phage phiIBB-PF7A. BMC Biotechnol. 2008, 8, 1–12. [Google Scholar] [CrossRef] [PubMed] [Green Version]
- Resch, A.; Fehrenbacher, B.; Eisele, K.; Schaller, M.; Friedrich, G. Phage release from biofilm and planktonic Staphylococcus aureus cells. FEMS Microbiol. Lett. 2005, 252, 89–96. [Google Scholar] [CrossRef] [PubMed] [Green Version]
- Garcia, K.C.O.D.; Correa, I.M.O.; Pereira, L.Q.; Silva, T.M.; Mioni, M.S.R.; Izidoro, A.C.M.; Bastos, I.H.V.; Gonçalves, G.A.M.; Okamoto, A.S.; Andreatti Filho, R.L. Bacteriophage use to control Salmonella biofilm on surfaces present in chicken slaughterhouses. Poult. Sci. 2017, 96, 3392–3398. [Google Scholar] [CrossRef] [PubMed]
- Gong, C.; Jiang, X. Application of bacteriophages to reduce Salmonella attachment and biofilms on hard surfaces. Poult. Sci. 2017, 96, 1838–1848. [Google Scholar] [CrossRef]
- Karaca, B.; Akcelik, N.; Akcelik, M. Effects of P22 bacteriophage on Salmonella enterica subsp. enterica serovar Typhimurium DMC4 strain biofilm formation and eradication. Arch. Biol. Sci. 2015, 67, 1361–1367. [Google Scholar] [CrossRef]
- Sadekuzzaman, M.; Mizan, M.F.R.; Yang, S.; Kim, H.S.; Ha, S.D. Application of bacteriophages for the inactivation of Salmonella spp. in biofilms. Food Sci. Technol. Int. 2018, 24, 424–433. [Google Scholar] [CrossRef] [PubMed]
- Dalmasso, M.; de Haas, E.; Neve, H.; Strain, R.; Cousin, F.J.; Stockdale, S.R.; Ross, R.P.; Hill, C. Isolation of a Novel Phage with Activity against Streptococcus mutans Biofilms. PLoS ONE 2015, 10, e0138651. [Google Scholar] [CrossRef] [Green Version]
- Atterbury, R.J.; Connerton, P.L.; Dodd, C.E.; Rees, C.E.; Connerton, I.F. Isolation and characterization of Campylobacter bacteriophages from retail poultry. Appl. Environ. Microbiol. 2003, 69, 4511–4518. [Google Scholar] [CrossRef] [Green Version]
- Binetti, A.G.; Reinheimer, J.A. Thermal and chemical inactivation of indigenous Streptococcus thermophilus bacteriophages isolated from Argentinian dairy plants. J. Food Prot. 2000, 63, 509–515. [Google Scholar] [CrossRef]
- Aprea, G.; D’Angelantonio, D.; Boni, A.; Connerton, P.; Connerton, I.; Scattolini, S.; Marotta, F.; Pomilio, F.; Migliorati, G.; D’Alterio, N.; et al. Isolation and Morphological Characterization of New Bacteriophages Active against Campylobacter jejuni. Am. J. Clin. Microbiol. Antimicrob. 2018, 1, 1004. [Google Scholar]
- Hsu, F.C.; Shieh, Y.S.; Sobsey, M.D. Enteric bacteriophages as potential fecal indicators in ground beef and poultry meat. J. Food Prot. 2002, 65, 93–99. [Google Scholar] [CrossRef]
- Surekhamol, I.S.; Deepa, G.D.; Somnath Pai, S.; Sreelakshmi, B.; Varghese, S.; Bright Singh, I.S. Isolation and characterization of broad spectrum bacteriophages lytic to Vibrio harveyi from shrimp farms of Kerala, India. Lett. Appl. Microbiol. 2013, 58, 197–204. [Google Scholar] [CrossRef]
- Whitman, P.A.; Marshall, R.T. Isolation of psychrophilic bacteriophage-host systems from refrigerated food products. Appl. Microbiol. 1971, 22, 220–223. [Google Scholar] [CrossRef]
- Lee, J.H.; Shin, H.; Son, B.; Heu, S.; Ryu, S. Characterization and complete genome sequence of a virulent bacteriophage B4 infecting food-borne pathogenic Bacillus cereus. Arch. Virol. 2013, 158, 2101–2108. [Google Scholar] [CrossRef]
- Oh, H.; Seo, D.J.; Jeon, S.B.; Park, H.; Jeong, S.; Chun, H.S.; Oh, M.; Choi, C. Isolation and Characterization of Bacillus cereus Bacteriophages from Foods and Soil. Food Environ. Virol. 2017, 9, 260–269. [Google Scholar] [CrossRef]
- Shin, H.; Bandara, N.; Shin, E.; Ryu, S.; Kim, K.P. Prevalence of Bacillus cereus bacteriophages in fermented foods and characterization of phage JBP901. Res. Microbiol. 2011, 162, 791–797. [Google Scholar] [CrossRef]
- Shin, H.; Lee, J.H.; Park, J.; Heu, S.; Ryu, S. Characterization and genome analysis of the Bacillus cereus-infecting bacteriophages BPS10C and BPS13. Arch. Virol. 2014, 159, 2171–2175. [Google Scholar] [CrossRef]
- Ackermann, H.W. Bacteriophage observations and evolution. Res. Microbiol. 2003, 154, 245–251. [Google Scholar] [CrossRef]
- Lee, W.J.; Billington, C.; Hudson, J.A.; Heinemann, J.A. Isolation and characterization of phages infecting Bacillus cereus. Lett. Appl. Microbiol. 2011, 52, 456–464. [Google Scholar] [CrossRef]
- Liu, A.; Liu, Y.; Peng, L.; Cai, X.; Shen, L.; Duan, M.; Ning, Y.; Liu, S.; Li, C.; Liu, Y.; et al. Characterization of the narrow-spectrum bacteriophage LSE7621 towards Salmonella Enteritidis and its biocontrol potential on lettuce and tofu. LWT 2020, 118, 108791. [Google Scholar] [CrossRef]
- Ford, B.E.; Sun, B.; Carpino, J.; Chapler, E.S.; Ching, J.; Choi, Y.; Jhun, K.; Kim, J.D.; Lallos, G.G.; Morgenstern, R.; et al. Frequency and fitness consequences of bacteriophage Φ6 host range mutations. PLoS ONE 2014, 9, e113078. [Google Scholar] [CrossRef] [PubMed] [Green Version]
- Keen, E.C. Tradeoffs in bacteriophage life histories. Bacteriophage 2014, 4, e28365. [Google Scholar] [CrossRef] [Green Version]
- de Jonge, P.A.; Nobrega, F.L.; Brouns, S.J.; Dutilh, B.E. Molecular and evolutionary determinants of bacteriophage host range. Trends Microbiol. 2019, 27, 51–63. [Google Scholar] [CrossRef]
- Ciacci, N.; D’Andrea, M.M.; Marmo, P.; Demattè, E.; Amisano, F.; Pilato, V.D.; Fraziano, M.; Lupetti, P.; Rossolini, G.M.; Thaller, M.C. Characterization of vB_Kpn_F48, a newly discovered lytic bacteriophage for Klebsiella pneumoniae of sequence type 101. Viruses 2018, 10, 482. [Google Scholar] [CrossRef] [PubMed] [Green Version]
- Wang, R.; Xing, S.; Zhao, F.; Li, P.; Mi, Z.; Shi, T.; Liu, H.; Tong, Y. Characterization and genome analysis of novel phage vB_EfaP_IME195 infecting Enterococcus faecalis. Virus Genes 2018, 54, 804–811. [Google Scholar] [CrossRef]
- Geng, P.; Tian, S.; Yuan, Z.; Hu, X. Identification and genomic comparison of temperate bacteriophages derived from emetic Bacillus cereus. PLoS ONE 2017, 12, e0184572. [Google Scholar] [CrossRef] [PubMed]
- Peng, Q.; Yuan, Y. Characterization of a novel phage infecting the pathogenic multidrug-resistant Bacillus cereus and functional analysis of its endolysin. Appl. Microbiol. Biotechnol. 2018, 102, 7901–7912. [Google Scholar] [CrossRef]
- Gillis, A.; Mahillon, J. Prevalence, genetic diversity, and host range of tectiviruses among members of the Bacillus cereus group. Appl. Environ. Microbiol. 2014, 80, 4138–4152. [Google Scholar] [CrossRef] [Green Version]
- Hantke, K. Major outer membrane protein of Escherichia coli k12 serve as receptors for the phage T2 (protein 1a) and 434 (protein 1b). Mol. Gen. Genet. 1978, 164, 131–135. [Google Scholar] [CrossRef]
- Capparelli, R.; Cuomo, P.; Papaianni, M.; Pagano, C.; Montone, A.M.I.; Ricciardelli, A.; Iannelli, D. Bacteriophage-Resistant Salmonella rissen: An In Vitro Mitigated Inflammatory Response. Viruses 2021, 13, 2468. [Google Scholar] [CrossRef]
- Ngangbam, A.K.; Devi, N.B.L. Molecular characterization of Salmonella bacteriophage isolated from natural environment and its potential role in phage therapy. IOSR J. Agric. Vet. Sci. 2012, 1, 7–11. [Google Scholar] [CrossRef]
- Klumpp, J.; Calendar, R.; Loessner, M.J. Complete Nucleotide Sequence and Molecular Characterization of Bacillus Phage TP21 and its Relatedness to Other Phages with the Same Name. Viruses 2010, 2, 961–971. [Google Scholar] [CrossRef]
- Yuan, Y.; Gao, M.; Peng, Q.; Wu, D.; Liu, P.; Wu, Y. Genomic analysis of a phage and prophage from a Bacillus thuringiensis strain. J. Gen. Virol. 2014, 95, 751–761. [Google Scholar] [CrossRef] [Green Version]
- NCBI Entrez Genome. Available online: www.ncbi.nlm.nih.gov/genomes/static/phg.html (accessed on 5 November 2008).
- Stewart, C.R.; Casjens, S.R.; Cresawn, S.G.; Houtz, J.M.; Smith, A.L.; Ford, M.E.; Peebles, C.L.; Hatfull, G.F.; Hendrix, R.W.; Huang, W.M.; et al. The genome of Bacillus subtilis bacteriophage SPO1. J. Mol. Biol. 2009, 388, 48–70. [Google Scholar] [CrossRef] [Green Version]
- Fouts, D.E.; Rasko, D.A.; Cer, R.Z.; Jiang, L.X.; Fedorova, N.B.; Shvartsbeyn, A.; Vamathevan, J.J.; Tallon, L.; Althoff, R.; Arbogast, T.S.; et al. Sequencing Bacillus anthracis typing phages gammaand cherry reveals a common ancestry. J. Bacteriol. 2006, 188, 3402–3408. [Google Scholar] [CrossRef] [Green Version]
- Minakhin, L.; Semenova, E.; Liu, J.; Vasilov, A.; Severinova, E.; Gabisonia, T.; Inman, R.; Mushegian, A.; Severinov, K. Genome sequence and gene expression of Bacillus anthracis bacteriophage Fah. J. Mol. Biol. 2005, 354, 1–15. [Google Scholar] [CrossRef]
- Schuch, R.; Fischetti, V.A. Detailed genomic analysis of the Wbeta and gamma phages infecting Bacillus anthracis: Implications for evolution of environmental fitness and antibiotic resistance. J. Bacteriol. 2006, 188, 3037–3051. [Google Scholar] [CrossRef] [Green Version]
- Moumen, B.; Nguen-The, C.; Sorokin, A. Sequence analysis of inducible prophage phIS3501 integrated into the haemolysin IIgene of Bacillus thuringiensis var israelensis ATCC35646. Genet. Res. Int. 2012, 2012, 543286. [Google Scholar]
- Faille, C.; Bénézech, T.; Midelet-Bourdin, G.; Lequette, Y.; Clarisse, M.; Ronse, G.; Ronse, A.; Slomianny, C. Sporulation of Bacillus spp. within biofilms: A potential source of contamination in food processing environments. Food Microbiol. 2014, 40, 64–74. [Google Scholar] [CrossRef]
- Huang, Y.; Flint, S.H.; Palmer, J.S. Bacillus cereus spores and toxins–The potential role of biofilms. Food Microbiol. 2020, 90, 103493. [Google Scholar] [CrossRef]
- Heringa, S.D.; Kim, J.K.; Jiang, X.; Doyle, M.P.; Erickson, M.C. Use of a mixture of bacteriophages for biological control of Salmonella enterica strains in compost. Appl. Environ. Microbiol. 2010, 76, 5327–5332. [Google Scholar] [CrossRef] [Green Version]
- Kinley, B. Prevalence and Biological Control of Salmonella Contamination in Rendering Plant Environments and the Finished Rendered Meals. Ph.D. Thesis, Clemson University, Clemson, SC, USA, 2009. [Google Scholar]
- Sharma, M.; Ryu, J.H.; Beuchat, L.R. Inactivation of Escherichia coli O157:H7 in biofilm on stainless steel by treatment with an alkaline cleaner and a bacteriophage. J. Appl. Microbiol. 2005, 99, 449–459. [Google Scholar] [CrossRef]
- Jamal, M.; Hussain, T.; Das, C.R.; Andleeb, S. Characterization of Siphoviridae phage Z and studying its efficacy against multidrug-resistant Klebsiella pneumoniae planktonic cells and biofilm. J. Med. Microbiol. 2015, 64, 454–462. [Google Scholar] [CrossRef] [Green Version]
- Abedon, S.T. Bacteriophage exploitation of bacterial biofilms: Phage preference for less mature targets? FEMS Microbiol. Lett. 2016, 363, 246. [Google Scholar] [CrossRef]
- Gutiérrez, D.; Rodríguez-Rubio, L.; Martínez, B.; Rodríguez, A.; García, P. Bacteriophages as weapons against bacterial biofilms in the food industry. Front. Microbiol. 2016, 7, 825. [Google Scholar] [CrossRef]
- Hudson, J.A.; Billington, C.; Carey-Smith, G.; Greening, G. Bacteriophages as biocontrol agents in food. J. Food Prot. 2005, 68, 426–437. [Google Scholar] [CrossRef]
- Donlan, R.M. Preventing biofilms of clinically relevant organisms using bacteriophage. Trends Microbiol. 2009, 17, 66–72. [Google Scholar] [CrossRef]
- Labrie, S.J.; Samson, J.E.; Moineau, S. Bacteriophage resistance mechanisms. Nat. Rev. Microbiol. 2010, 8, 317–327. [Google Scholar] [CrossRef]
- Samson, J.E.; Magadan, A.H.; Sabri, M.; Moineau, S. Revenge of the phages: Defeating bacterial defences. Nat. Rev. Microbiol. 2013, 11, 675–687. [Google Scholar] [CrossRef]
- Gödeke, J.; Paul, K.; Lassak, J.; Thormann, K.M. Phage-induced lysis enhances biofilm formation in Shewanella oneidensis MR-1. ISME J. 2011, 5, 613–626. [Google Scholar] [CrossRef] [PubMed] [Green Version]
- Gdoura-Ben Amor, M.; Siala, M.; Zayani, M.; Grosset, N.; Smaoui, S.; Messadi-Akrout, F.; Baron, F.; Jan, S.; Gautier, M.; Gdoura, R. Isolation, Identification, Prevalence, and Genetic Diversity of Bacillus cereus Group Bacteria from Different Foodstuffs in Tunisia. Front. Microbiol. 2018, 9, 447. [Google Scholar] [CrossRef] [Green Version]
- Adams, M. Bacteriophages; Interscience Publishers: New York, NY, USA, 1959; pp. 49–62. [Google Scholar]
- Wommack, K.E.; Williamson, K.E.; Helton, R.R.; Bench, S.R.; Winget, D.M. Methods for the isolation of viruses from environmental samples. In Bacteriophages; Humana Press: New York, NY, USA, 2009; pp. 3–14. [Google Scholar]
- Sambrook, J.; Russell, D. Molecular Cloning: A Laboratory Manual, 3rd ed.; Cold Spring Harbor Laboratory Press: New York, NY, USA, 2001. [Google Scholar]
- Jan, S.; Brunet, N.; Techer, C.; Le Marechal, C.; Kone, A.Z.; Grosset, N.; Cochet, M.F.; Gillard, A.; Gautier, M.; Puterflam, J.; et al. Biodiversity of psychrotrophic bacteria of the Bacillus cereus group collected on farm and in egg product industry. Food Microbiol. 2011, 28, 261–265. [Google Scholar] [CrossRef]
- Baron, F.; Cochet, M.F.; Ablain, W.; Grosset, N.; Madec, M.N.; Gonnet, F.; Jan, S.; Gautier, M. Rapid and cost-effective method for microorganism enumeration based on miniaturization of the conventional plate-counting technique. Le Lait 2006, 86, 251–257. [Google Scholar] [CrossRef] [Green Version]

| Pooled Sample | Number of Isolated Phages | Isolated Phages |
|---|---|---|
| P1 | 16 | Ø1BC13; Ø1BC14; Ø1BC18; Ø1BC27; Ø1BC28; Ø1BC396; Ø1BC478; Ø1BC499; Ø1BC2893; Ø1BC2976; Ø1BC3296; Ø1BC3940; Ø1BC3990; Ø1BC4663; Ø1BC4785; and Ø1BC4851 |
| P2 | 15 | Ø2BC12; Ø2BC13; Ø2BC14; Ø2BC27; Ø2BC28; Ø2BC396; Ø2BC2893; Ø2BC2976; Ø2BC3296; Ø2BC3990; Ø2BC4663; Ø2BC4785; Ø2BC4851; Ø2BC4855; and Ø2BC5659 |
| P3 | 19 | Ø3BC13; Ø3BC14; Ø3BC18; Ø3BC24; Ø3BC27; Ø3BC396; Ø3BC478; Ø3BC2893; Ø3BC3296; Ø3BC3940; Ø3BC3990; Ø3BC4160; Ø3BC4165; Ø3BC4663; Ø3BC4785; Ø3BC4851; Ø3BC4855; Ø3BC5659; and Ø3BCE10 |
| P4 | 12 | Ø4BC13; Ø4BC24; Ø4BC27; Ø4BC396; Ø4BC478; Ø4BC2893; Ø4BC3990; Ø4BC4663(1); Ø4BC4663(2); Ø4BC4785; Ø4BC4851; and Ø4BCE10 |
| Isolated Phages | Percentage Lysis (%) |
|---|---|
| Ø1BC3990 | 13.2 |
| Ø1BC478 | 13.2 |
| Ø3BC4663 | 12.6 |
| Ø2BC4663 | 10.3 |
| Ø4BC4663(2) | 10.3 |
| Ø4BC4663(1) | 9.7 |
| Ø1BC4663 | 8.6 |
| Phages | Characteristics | Total Length (±Standard Deviation) (nm) | Head Diameter (±Standard Deviation) (nm) | Family |
|---|---|---|---|---|
| Ø1BC478 | icosahedral head, non-contarctile tail | 330.5 ± 90.2 | 75.0 ± 31.8 | Siphoviridae |
| Ø1BC3990 | 411.4 ± 86.9 | 125.5 ± 20.8 | ||
| Ø2BC4663 | 340.0 ± 93.8 | 113.3 ± 38.9 | ||
| Ø3BC4663 | 355.6 ± 59.6 | 86.4 ± 27.6 | ||
| Ø4BC4663(1) | 200.3 ± 74.9 | 87.5 ± 40.3 | ||
| Ø4BC4663(2) | 337.7 ± 60.8 | 112.0 ± 29.9 | ||
| Ø1BC4663 | 314.2 ± 87.9 | 97.61 ± 18.9 |
Publisher’s Note: MDPI stays neutral with regard to jurisdictional claims in published maps and institutional affiliations. |
© 2022 by the authors. Licensee MDPI, Basel, Switzerland. This article is an open access article distributed under the terms and conditions of the Creative Commons Attribution (CC BY) license (https://creativecommons.org/licenses/by/4.0/).
Share and Cite
Gdoura-Ben Amor, M.; Culot, A.; Techer, C.; AlReshidi, M.; Adnan, M.; Jan, S.; Baron, F.; Grosset, N.; Snoussi, M.; Gdoura, R.; et al. Isolation, Partial Characterization and Application of Bacteriophages in Eradicating Biofilm Formation by Bacillus cereus on Stainless Steel Surfaces in Food Processing Facilities. Pathogens 2022, 11, 872. https://doi.org/10.3390/pathogens11080872
Gdoura-Ben Amor M, Culot A, Techer C, AlReshidi M, Adnan M, Jan S, Baron F, Grosset N, Snoussi M, Gdoura R, et al. Isolation, Partial Characterization and Application of Bacteriophages in Eradicating Biofilm Formation by Bacillus cereus on Stainless Steel Surfaces in Food Processing Facilities. Pathogens. 2022; 11(8):872. https://doi.org/10.3390/pathogens11080872
Chicago/Turabian StyleGdoura-Ben Amor, Maroua, Antoine Culot, Clarisse Techer, Mousa AlReshidi, Mohd Adnan, Sophie Jan, Florence Baron, Noël Grosset, Mejdi Snoussi, Radhouane Gdoura, and et al. 2022. "Isolation, Partial Characterization and Application of Bacteriophages in Eradicating Biofilm Formation by Bacillus cereus on Stainless Steel Surfaces in Food Processing Facilities" Pathogens 11, no. 8: 872. https://doi.org/10.3390/pathogens11080872
APA StyleGdoura-Ben Amor, M., Culot, A., Techer, C., AlReshidi, M., Adnan, M., Jan, S., Baron, F., Grosset, N., Snoussi, M., Gdoura, R., & Gautier, M. (2022). Isolation, Partial Characterization and Application of Bacteriophages in Eradicating Biofilm Formation by Bacillus cereus on Stainless Steel Surfaces in Food Processing Facilities. Pathogens, 11(8), 872. https://doi.org/10.3390/pathogens11080872

